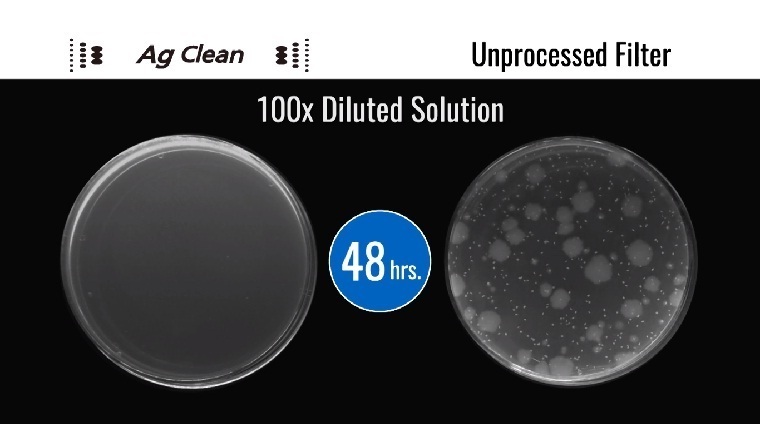
đánh bay mùi tủ lạnh với công nghệ ag clean của panasonic

Một trong những ưu điểm nổi bật của tủ lạnh Panasonic là khả năng kháng khuẩn, khử mùi hiệu quả với công nghệ Ag Clean. Vậy công nghệ Ag Clean là gì, lợi ích ra sao? Hãy cùng đi tìm câu trả lời với Muadienmay.vn nhé.
1 Công nghệ Ag Clean là gì?
Ag Clean là công nghệ sử dụng các ion bạc Ag+ trong quá trình kháng khuẩn và khử mùi bên trong tủ lạnh. Tại sao lại là ion bạc? Theo các nhà khoa học, ion bạc có khả năng tiêu diệt đến 99.9% nấm mốc và vi khuẩn nhờ kiềm hãm sự phát sinh của vi khuẩn gây mùi từ thực phẩm, đồng thời vô hiệu hóa quá trình hô hấp của tế bào vi khuẩn, mang đến bầu không khí trong lành, sạch khuẩn, giúp thực phẩm tươi lâu hơn, hạn chế được mùi hôi bên trong tủ lạnh.

2 Lợi ích của công nghệ Ag Clean
So với bộ lọc thông thường được quan sát trong vòng 48 giờ, bộ lọc công nghệ Ag Clean với ion bạc của tủ lạnh Panasonic có khả năng ức chế hoạt động của vi khuẩn xuống mức gần như bằng 0, giúp cho thực phẩm, đặc biệt là thực phẩm tươi sống giữ được tươi ngon và không bị biến chất trong thời gian dài, bảo vệ sức khỏe cho gia đình bạn.
Ngoài ra công nghệ Ag Clean có thể khử sạch đi những mùi hôi khác nhau của thực phẩm nhờ vào 2 bộ lọc là bộ lọc sinh học gốc Nito (khử mùi thịt, cá) và bộ lọc sinh học Sulfur (khử mùi rau quả) hoạt động mạnh mẽ, tích cực. Giờ đây nỗi ám ảnh về mùi hôi khó chịu trong tủ lạnh hoặc thực phẩm bị lẫn mùi vào nhau sẽ không còn khiến bạn phải lo lắng và bận tâm nữa.

Trong năm 2017, Panasonic đã cho ra đời 2 dòng tủ lạnh được tích hợp công nghệ Ag Clean, giúp bạn có thêm sự lựa chọn cho một chiếc tủ lạnh đời mới, ứng dụng công nghệ hiện đại. Muadienmay.vn hi vọng bài viết này đã mang đến cho bạn những thông tin hữu ích về công nghệ Ag Clean trên tủ lạnh Panasonic. Nếu bạn có thắc mắc hoặc cần tư vấn thêm hãy cho chúng tôi biết vào phần bình luận bên dưới bài viết nhé.
